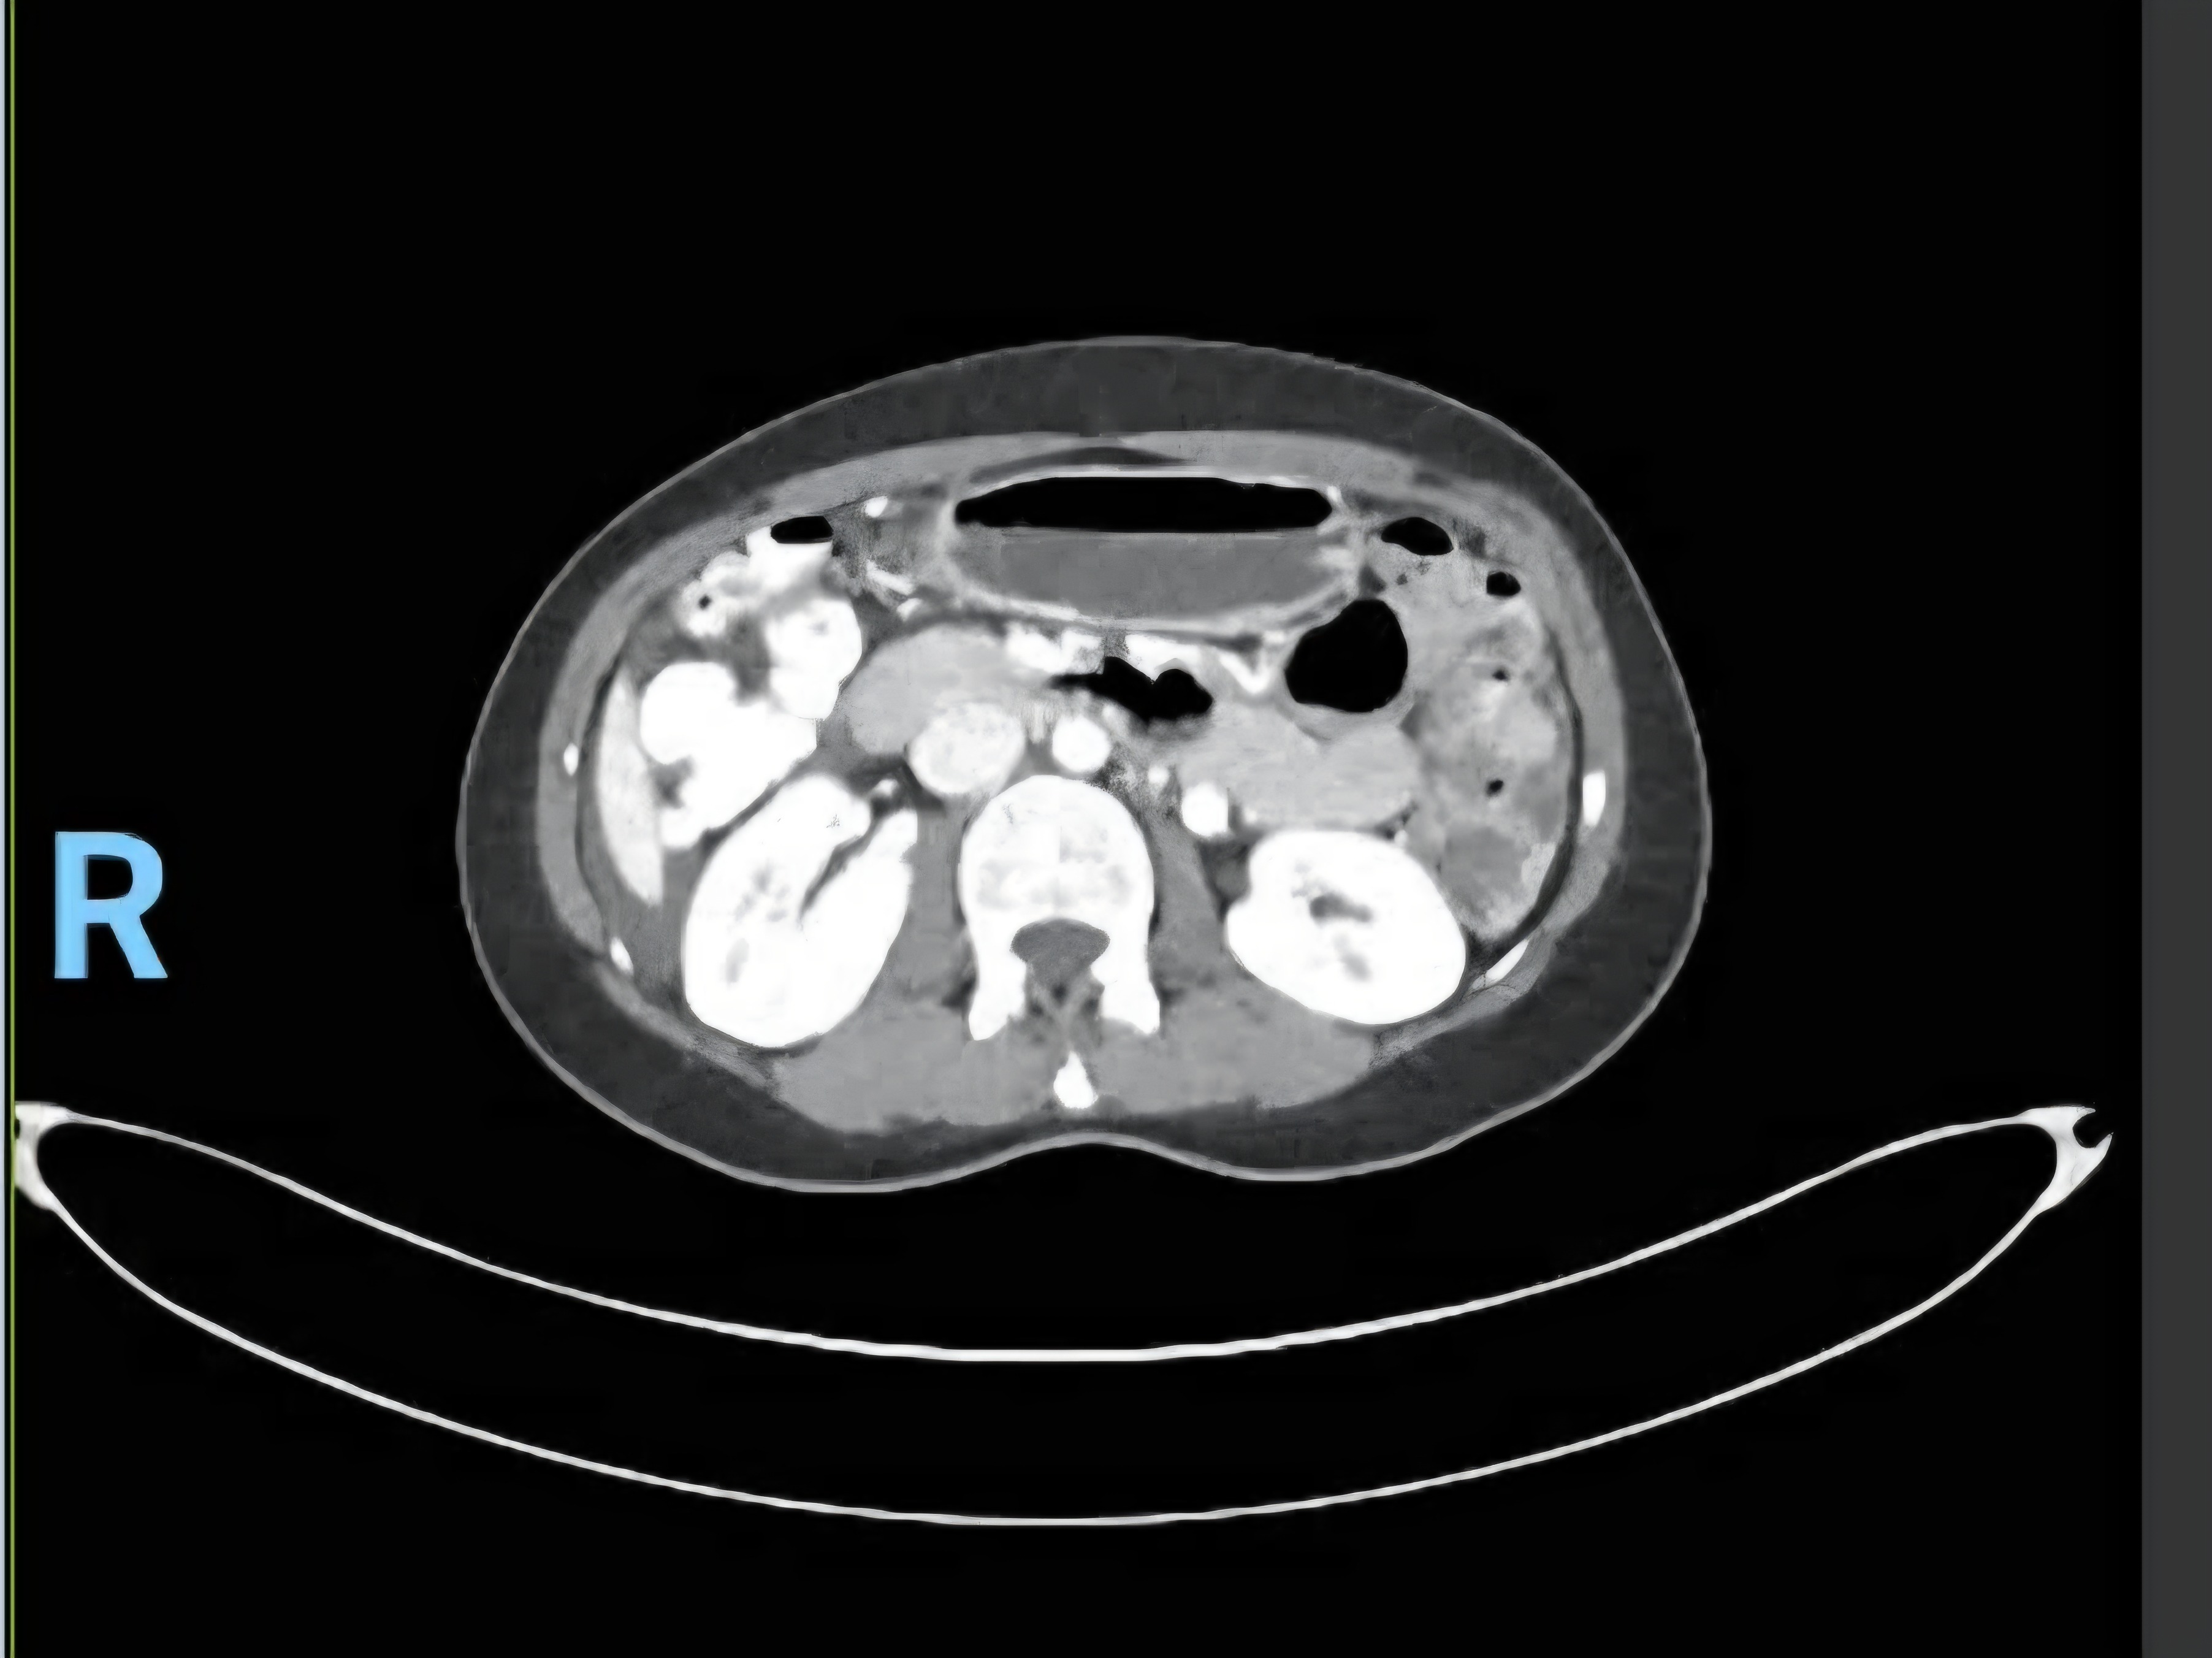

- M
- B

Hello, for those who know me and for those who don't, my name is Emma (Macky) An, a loving wife and loving mother to my two beautiful daughters (2 & 5 years old). This is my story.
Back in 2018, I was diagnosed with Stage 2 ovarian cancer, had surgery, and survived it. Yes, I was a cancer survivor! Unfortunately, devastating news has been brought to me. After 7 years, the cancer is back and more aggressive. This time, I was diagnosed with re-occurrence (stage 4) ovarian cancer that has spread to the organs of my body, particularly my lungs and liver. It is the most devastating news for me and my family.
Soon, I will be scheduled for a 12-hour major surgery, and if I survive this, I will be doing a series of chemotherapy. This is going to be another battle, a long journey for me. I am scared, but I am determined to fight this one for my two daughters.
One of the burdens I am facing right now is the restricted funds of my health insurance. There will be a financial strain towards my recovery.
So, I am asking anyone who has a good heart to support me with prayers and financially so I can live for my two daughters.
Thank you to all of you who understand and help. May God bless each one of you!